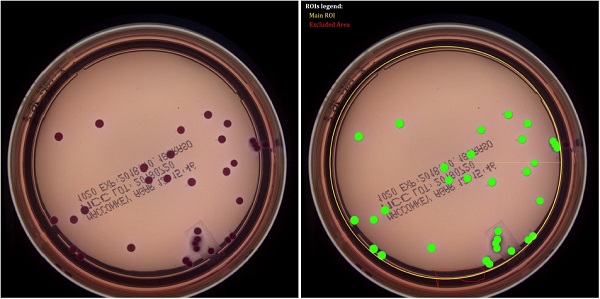

자동 콜로니 카운터(auto colony counter)로 균수 측정을 간편하게~!! 본문
안녕하세요, 켐코코리아 주식회사입니다.
오늘은 자동 콜로니 카운터 Quantica 500을 이용한 균수 측정을 소개합니다.

자동 콜로니 카운터는 0.05mm의 작은 크기도 측정이 가능하고, 0.5초만에 수많은 콜로니를 전부 계수하는 장비입니다.
3가지 조명 모드로 형광배지, 발색배지 등등 배지 색이나 균 종류에 맞춰 계수가 가능합니다.
몇가지 예시를 보여드리겠습니다.

밝은 투명 배지에 흰색 콜로니입니다.
150개의 콜로니가 0.5초만에 계수됩니다!!
흰색 콜로니는 세는 것도 많이 어렵고 잘 보이지 않아 빛을 세게 켜서 확인하고는 하는데, Quantica 500과 함께라면 눈 건강까지 챙길 수 있답니다.
MacConkey dark와 같은 어두운 배지도 Quantica 500이라면 문제 없습니다.
조명 모드와 밝기 조절을 통해서 어떤 배지의 콜로니도 다 잡아내는 Quantica 500!!!

Blood agar배지 역시 Quantica 500은 전부 찾아냅니다.
이 모든 작업이 0.5초만에 이뤄진다는 사실!!
고해상도 카메라로 촬영한 사진이 저장되기 때문에 페트리 디시를 폐기해도 다시 확인이 가능하고, 보고서나 논문에 첨부하기 위한 사진도 아주 잘 촬영된답니다.
그리고 페트리 디시에서 콜로니 수만 세면 끝나는 것이 아니라... 배지에 분주한 용량, 희석배수 등등 곱하기 나누기를 해야하는 번거로움이 남죠??
Quantica 500은 미리 희석배수와 분주한 용량을 입력하면 CFU 계산까지!
보고서로 한번에 출력이 가능합니다!!
이제 균수 측정은 Quantica 500에 맡기세요!!
지금 바로 켐코코리아로 연락주세요!
켐코코리아 주식회사
Tel. 043-215-2012
e-mail. ck@chemcokorea.com
'바이오 실험장비' 카테고리의 다른 글
| MBS 방법과 기존 미생물 분석 방법의 비교 논문 (0) | 2021.06.01 |
|---|---|
| MBS 미생물 검출 키트와 전통적인 방법의 비교 (0) | 2021.05.28 |
| 전처리 필요없는 미생물 분석 키트 MBS-HACCP&WATER EASY TEST를 소개합니다 (0) | 2021.05.27 |
| 0.5초만에 모든 것을 확인!!!!! Automatic Colony Counter!!!!!! (0) | 2021.05.17 |
| 획기적인 세균계수기(Colony Counter)를 소개합니다. (0) | 2021.03.19 |